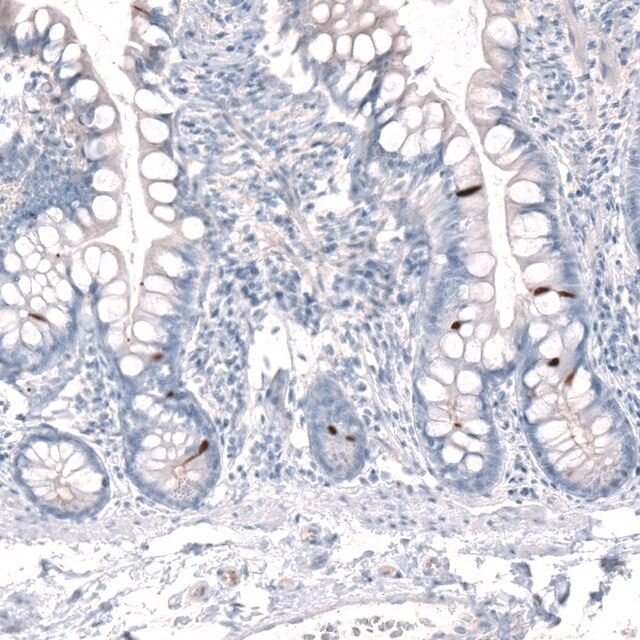

您的位置:首页 > 产品中心 > 抗-CHAT 兔抗
抗-CHAT 兔抗
Anti-CHAT antibody produced in rabbit

| 产品编号: | 3353193 |
| 规格: | Prestige Antibodies® Powered by Atlas Antibodies, affinity isolated antibody, buffered aqueous glycerol solution |
| 包装规格: | 25 μL,100 μL |
| 产品类别: | 进口试剂 |
| 品牌: | Sigma-Aldrich |
| 优惠价: | 立即咨询 |
产品别名
抗-CHAT 兔抗
Anti-CHAT antibody produced in rabbit
基本信息
| Human Protein Atlas Number【人类蛋白质图谱编号】 | HPA048547 Human Protein Atlas characterization data |
| Immunogen【免疫原】 | 胆碱O-乙酰转移酶 |
| Application【应用】 | 由Atlas Antibodies提供支持的所有Prestige抗体均由人类蛋白图谱(HPA)项目(www.proteinatlas.org)开发和验证,因此得到了业内最广泛的表征支持。 人类蛋白图谱项目可以细分为三个方面:人体组织图谱、癌症图谱和人类细胞图谱。在组织和癌症图谱项目支持下产生的抗体已通过免疫组化针对数百种正常和疾病组织进行了测试,并且通过人类细胞图谱项目的近期努力也使得其中的多种通过免疫荧光在组织以及亚细胞水平进行了表征以,并与人类蛋白组进行了比对。通过单击图像库链接,可在人类蛋白质图谱(HPA)站点上查看对这些图像和大量数据集的收录。如需查看有关Prestige Antibodies和HPA的实验方法和其他有用信息,请访问sigma.com/prestige。 |
| Features and Benefits【特点和优势】 | Prestige Antibodies®是经过高度表征和广泛验证的抗体,同时还有一个优点是其每个靶标的所有可用表征数据都可以通过位于此页面顶部产品名称下方的人类蛋白质图谱门户进行访问。Prestige Antibodies®对其他蛋白质的独特性和低交叉反应性是通过严密的抗原区域选择、亲和纯化和严格的选择来实现的。针对每一个Prestige Antibody都存在有对应的Prestige抗原对照,并可在链接区域内找到。 每个Prestige Antibody都是按照以下方法进行测试的:
|
| Linkage【联系】 | 对应抗原 APREST86792。 |
| Physical form【外形】 | 在含有 40% 甘油和 0.02% 叠氮化钠的磷酸盐缓冲盐水(pH 7.2)中的溶液。 |
| Legal Information【法律信息】 | Prestige Antibodies is a registered trademark of sigma-aldrich Co. LLC |
产品性质
| biological source【生物来源】 | rabbit |
| Quality Level【质量水平】 | 100 |
| conjugate【偶联物】 | unconjugated |
| antibody form【抗体形式】 | affinity isolated antibody |
| antibody product type | primary antibodies |
| clone【克隆】 | polyclonal |
| product line【产品线】 | Prestige Antibodies® Powered by Atlas Antibodies |
| form【形式】 | buffered aqueous glycerol solution |
| species reactivity | human, mouse |
| packaging【包装】 | antibody small pack of 25 μL |
| technique(s) | immunohistochemistry: 1:500-1:1000 |
| immunogen sequence【免疫原序列】 | GLFSSYRLPGHTQDTLVAQNSSIMPEPEHVIVACCNQFFVLDVVINFRRLSEGDLFTQLRKIVKMASNEDERLPPIGLLTSDGRSEWAEARTVLVKDSTN |
| UniProt accession no.【UniProt登记号】 | P28329 |
| shipped in【运输】 | wet ice |
| storage temp.【储存温度】 | −20℃ |
| Gene Information | human ... CHAT(1103) |
产品说明
| Disclaimer【免责声明】 | 除非我们的产品目录或产品附带的其他公司文档另有说明,否则我们的产品仅供研究使用,不得用于任何其他目的,包括但不限于未经授权的商业用途、体外诊断用途、离体或体内治疗用途或任何类型的消费或应用于人类或动物。 |
安全信息
| Storage Class Code【储存分类代码】 | 10 - Combustible liquids |
| WGK | WGK 1 |